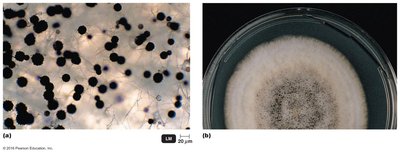
Aerial and vegetative hyphae of Aspergillus niger

Back
BackThe Eukaryotes: Fungi, Algae, Protozoa, and Helminths – Study Notes
Study Guide - Smart Notes

The Eukaryotes: Fungi, Algae, Protozoa, and Helminths
Fungi
Fungi are a diverse group of eukaryotic organisms that play essential roles in decomposition, nutrient cycling, and as pathogens. The study of fungi is known as mycology.
Nutrition: Fungi are chemoheterotrophs, obtaining nutrients by absorbing dissolved organic matter.
Habitat: They decompose organic matter and can be aerobic or facultative anaerobes.
Comparison of Fungi and Bacteria
Fungi and bacteria differ in several fundamental ways:
Feature | Fungi | Bacteria |
|---|---|---|
Cell Type | Eukaryotic | Prokaryotic |
Cell Membrane | Sterols present | Sterols absent (except in Mycoplasma) |
Cell Wall | Glucans, mannans, chitin (no peptidoglycan) | Peptidoglycan |
Spores | Sexual and asexual reproductive spores | Endospores (for reproduction), some asexual reproductive spores |
Metabolism | Heterotrophic, aerobic, facultatively anaerobic | Heterotrophic, autotrophic, aerobic, facultatively anaerobic, anaerobic |

Vegetative Structures
Fungi exist in various forms:
Molds and fleshy fungi: The main body (thallus) consists of hyphae (filaments). A mass of hyphae is called a mycelium.
Hyphae types: Septate hyphae have cross-walls; coenocytic hyphae lack septa.
Vegetative hyphae absorb nutrients; aerial hyphae are involved in reproduction.

Yeasts
Yeasts are nonfilamentous, unicellular fungi. They reproduce by:
Budding: Uneven division of the parent cell.
Fission: Even division to produce two new cells.
Dimorphic fungi: Exhibit yeastlike growth at 37°C and moldlike growth at 25°C.


Fungal Life Cycle
Fungi reproduce both sexually and asexually via spores:
Asexual spores: Produced by mitosis; types include conidiospores, arthroconidia, blastoconidia, chlamydoconidia, and sporangiospores.
Sexual spores: Involve fusion of nuclei from two mating strains and include three phases: plasmogamy, karyogamy, and meiosis.









Nutritional Adaptations
Grow best at pH 5 (more acidic than most bacteria).
Resistant to high sugar and salt concentrations (osmotic pressure).
Can grow in low moisture environments.
Capable of metabolizing complex carbohydrates.
Medically Important Fungi
Zygomycota: Conjugation fungi with coenocytic hyphae; produce sporangiospores (asexual) and zygospores (sexual).
Microsporidia: Obligate intracellular parasites, lack mitochondria, sexual reproduction not observed.
Ascomycota: Sac fungi with septate hyphae; produce conidiospores (asexual) and ascospores (sexual) in an ascus.
Basidiomycota: Club fungi with septate hyphae; produce conidiospores (asexual) and basidiospores (sexual) on a basidium.




Fungal Diseases (Mycoses)
Systemic mycoses: Deep within the body.
Subcutaneous mycoses: Beneath the skin.
Cutaneous mycoses: Affect hair, skin, and nails.
Superficial mycoses: Localized, e.g., hair shafts.
Opportunistic mycoses: Normally harmless fungi that become pathogenic in compromised hosts.
Economic Effects of Fungi
Saccharomyces cerevisiae: Used in bread, wine, and hepatitis B vaccine production.
Trichoderma: Produces cellulase for industry.
Taxomyces: Source of taxol (anticancer drug).
Entomophaga: Used in biocontrol of pests.
Coniothyrium minitans: Kills crop fungi.
Paecilomyces: Kills termites.
Lichens
Lichens are mutualistic associations between a green alga (or cyanobacterium) and a fungus. They are important pioneers in ecological succession and have economic uses.
Types: Crustose (encrusted), foliose (leaflike), fruticose (fingerlike).
Structure: Thallus consists of medulla (hyphae around algal cells), rhizines (holdfasts), and cortex (protective layer).


Alga: Produces carbohydrates via photosynthesis.
Fungus: Provides structure and protection.
Economic importance: Dyes, antimicrobials (e.g., Usnea), litmus, and food for herbivores.
Algae
Algae are a diverse group of mostly aquatic, photosynthetic eukaryotes. They are not a formal taxonomic group but are classified based on their pigments, cell wall composition, and storage products.
Structure: Multicellular algae have a thallus with holdfasts, stipes, and blades.
Reproduction: All reproduce asexually; multicellular forms may also reproduce sexually via alternation of generations.
Group | Cell Wall | Storage Material | Pathogenicity |
|---|---|---|---|
Brown Algae | Cellulose, alginic acid | Carbohydrate | None |
Diatoms | Pectin, silica | Oil | Domoic acid toxin |
Dinoflagellates | Cellulose in plasma membrane | Starch | Saxitoxins (paralytic shellfish poisoning) |
Water Molds | Cellulose | None | Parasitic |
Red Algae | Cellulose | Glucose polymer | Some produce toxins |
Green Algae | Cellulose | Starch | None |

Habitats and Adaptations
Distribution depends on light, nutrients, and attachment surfaces.
Major contributors to aquatic food webs and oxygen production (up to 80% of Earth's O2).

Selected Phyla of Algae
Brown algae (kelp): Multicellular, produce algin (food thickener).
Red algae: Multicellular, source of agar and carrageenan, some produce toxins.
Green algae: Unicellular or multicellular, contain chlorophyll a and b, store starch, ancestors of land plants.
Diatoms: Unicellular or filamentous, pectin and silica cell walls, produce domoic acid (neurotoxin).
Dinoflagellates: Unicellular, cellulose in plasma membrane, produce saxitoxins (paralytic shellfish poisoning).
Oomycota (water molds): Cellulose cell walls, decomposers and plant parasites (e.g., Phytophthora infestans caused Irish potato blight).






Roles of Algae in Nature
Fix CO2 into organic molecules via photosynthesis.
Produce oxygen and serve as the base of aquatic food chains.
Algal blooms can release toxins or deplete oxygen in water bodies.
Some algae are symbionts with animals.
Protozoa
Protozoa are unicellular, eukaryotic organisms found in water and soil. They exhibit animal-like nutrition and complex life cycles.
Feeding form: Trophozoite
Reproduction: Asexual (fission, budding, schizogony); sexual (conjugation)
Cyst formation: Some form cysts to survive harsh conditions.
Characteristics of Protozoa
Require abundant water.
Many have a pellicle (protective outer layer).
Specialized feeding structures: ciliates use cilia to direct food, amebae use pseudopods for phagocytosis.
Digest food in vacuoles; waste eliminated via an anal pore.
Medically Important Protozoa
Diplomonads: No mitochondria, multiple flagella (e.g., Giardia).
Parabasalids: Undulating membrane, no cyst stage (e.g., Trichomonas vaginalis).
Euglenozoa: Photoautotrophs or facultative chemotrophs; includes hemoflagellates (transmitted by insects).
Amebae: Move by pseudopods (e.g., Entamoeba histolytica causes dysentery).
Apicomplexa: Nonmotile, obligate intracellular parasites with complex life cycles (e.g., Plasmodium causes malaria).
Ciliates: Move by cilia; Balantidium coli is the only human parasite in this group.
Helminths
Helminths are multicellular parasitic worms, including flatworms (Platyhelminthes) and roundworms (Nematoda). They are specialized for parasitic life, often with reduced digestive and nervous systems and complex reproductive strategies.
Life cycle: May be dioecious (separate sexes) or monoecious (hermaphroditic). Typical stages: egg → larva(e) → adult.
Platyhelminths: Includes trematodes (flukes) and cestodes (tapeworms).
Nematodes: Roundworms, often with complete digestive systems; can be free-living or parasitic.
Arthropods as Vectors
Arthropods are animals with segmented bodies, exoskeletons, and jointed legs. Some act as vectors, transmitting pathogenic microorganisms.
Classes: Arachnida (eight legs), Crustacea (four antennae), Insecta (six legs).
Transmission: Mechanical (passive) or biological (pathogen multiplies in vector).
Definitive host: Where the microbe's sexual reproduction occurs.
